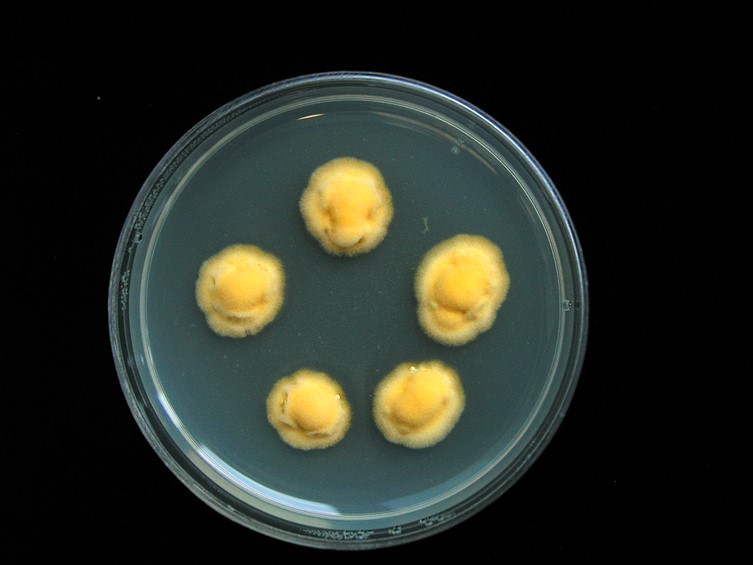

Habitat:
Underside of dicotyledonous leaves or monocotyledonous leaves.
Host:
Whitefly nymphs (Aleyrodidae).
Description:
 Sexual morph: stromata usually discoid (to stud-shaped) upper surface almost plane, edge vertical or rounded, sometimes umbilicate in the center when a solitary ostiole is present, with or without a thin, fibrillose hypothallus, up to 4 mm diam and up to 2 mm high, orange-red, pale orange to dark orange or orange red, internally yellowish white.
Sexual morph: stromata usually discoid (to stud-shaped) upper surface almost plane, edge vertical or rounded, sometimes umbilicate in the center when a solitary ostiole is present, with or without a thin, fibrillose hypothallus, up to 4 mm diam and up to 2 mm high, orange-red, pale orange to dark orange or orange red, internally yellowish white.  Perithecia scattered, crowded, slightly projecting, ostioles ca 100 m diam., flask-shaped, ca 300-350 µm deep, ca 130-150 µm diam.
Perithecia scattered, crowded, slightly projecting, ostioles ca 100 m diam., flask-shaped, ca 300-350 µm deep, ca 130-150 µm diam.  Asci cylindric up to 180 µm long and 7-8 µm diam.
Asci cylindric up to 180 µm long and 7-8 µm diam.  Ascospores 8-spored, elongate clavate, blunt at one end, tapering at the other end, 75-80 µm long, 2.5 µm diam.
Ascospores 8-spored, elongate clavate, blunt at one end, tapering at the other end, 75-80 µm long, 2.5 µm diam.  Asexual morph: stromata flattened or laterally oval, 300 µm diam. Conidioma each in center or circularly arranged, dark orange to red-brown, oval up to 500 µm deep, 450 µm diam.
Asexual morph: stromata flattened or laterally oval, 300 µm diam. Conidioma each in center or circularly arranged, dark orange to red-brown, oval up to 500 µm deep, 450 µm diam.  Paraphyses linear, up to 250 µm long, 1-1.5 µm diam.
Paraphyses linear, up to 250 µm long, 1-1.5 µm diam.  Conidia fusoid, 10-12.5 × 1.5-2 µm.
Conidia fusoid, 10-12.5 × 1.5-2 µm.
Culture characteristics:
Colonies on PDA compact, convex, surface wrinkled and flat at the margins, attaining a diam of 8–9 mm in 3 wk, pale orange, pale yellow conidial masses.
Colonies on PDA compact, convex, surface wrinkled and flat at the margins, attaining a diam of 8–9 mm in 3 wk, pale orange, pale yellow conidial masses.
Reference:
Hywel-Jones NL, Evans HC (1993). Taxonomy and ecology of Hypocrella discoidea and its anamorph, Aschersonia samoensis. Mycological Research 97: 871–876.
DOI: https://doi.org/10.1016/S0953-7562(09)81165-9Petch T (1921). Studies in entomogenous fungi: II. The genera Hypocrella and Aschersonia. Annals of the Royal Botanic Gardens Peredinaya 7: 167–278.
Species |
Strain |
Compound |
Pubchem CID |
Biological activity |
Reference |
|---|
|
Strain |
ITS | β-tubulin |
|---|---|---|
| BCC 2203 | EU409588 | EU409572 |
| BCC 23129 | EU409588 | EU409571 |
| BCC 8239 | DQ365843 | EU409573 |